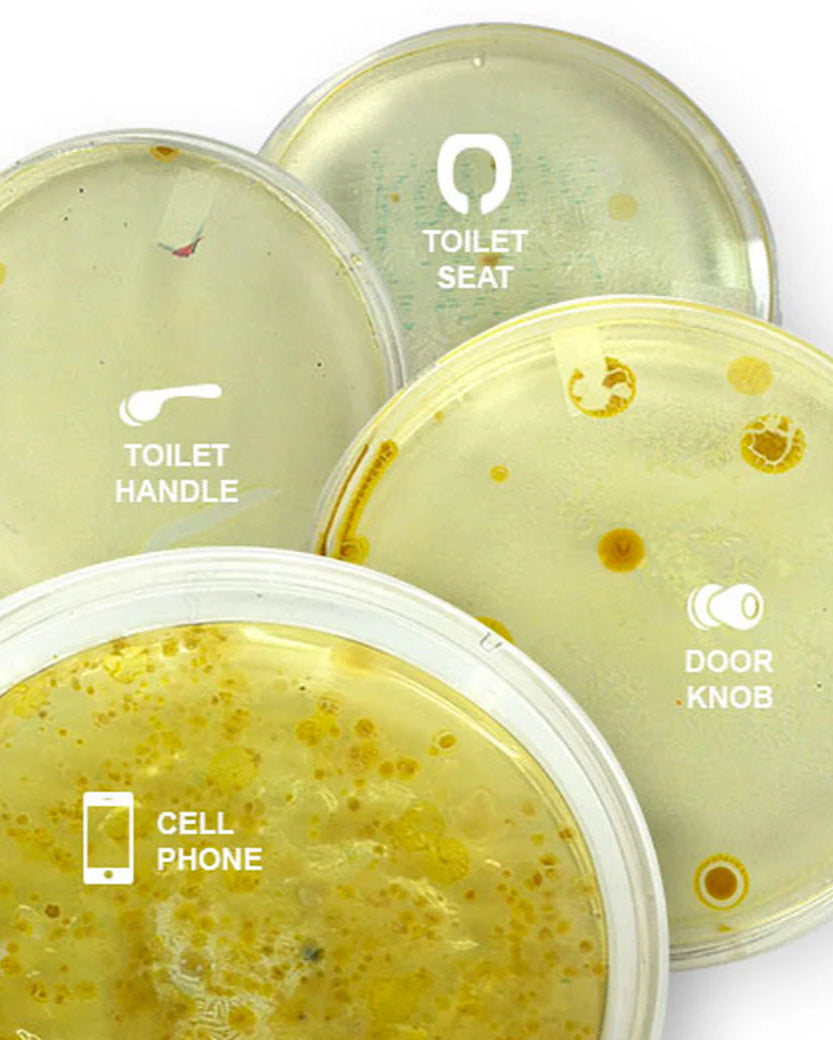

PhoneSoap 3: UV Phone Sanitizer And Charger
The Original UV Phone Sanitizer and Charger - PhoneSoap 3 | PhoneSoap
PhoneSoap 3 disinfects using medical grade UV-C light technology.
- 99.99% 360-degree disinfection in 10 minutes
- Sanitize small items from phones to watches to personal care items
- USB and USB-C charging ports
How germy is your phone?
Your Phone harbors harmful bacteria and viruses. PhoneSoap uses powerful UV-C lights to kill germs such as Salmonella, E. coli, MRSA, Staphylococcus, Coronavirus 229E that are growing on your every day items. See the 99.99% difference yourself.
Salmonella
Symptoms include diarrhea, fever, abdominal cramps, nausea, vomiting, and headache.
E. coli
causes cramps, bloody diarrhea, fever, or kidney failure
Salmonella
Symptoms include diarrhea, fever, abdominal cramps, nausea, vomiting, and headache.
E. coli
causes cramps, bloody diarrhea, fever, or kidney failure
Rhinovirus (cold)
Runny nose, sneezing, sore throat, cough, mild fever and fatigue.
Staphylococcus
causes infections, food poisoning, pneumonia, and organ failure.


Rhinovirus (cold)
Runny nose, sneezing, sore throat, cough, mild fever and fatigue.
Staphylococcus
causes infections, food poisoning, pneumonia, and organ failure.
A Petri Dish in your Pocket
Your phone goes everywhere—bathrooms, grocery stores, gym floors—collecting bacteria along the way. Every tap, swipe, and call transfers germs, turning your device into a petri dish in your pocket.
Need to sanitize larger items? Checkout the HomeSoap large capacity UV-C sanitizer.
PhoneSoap Features

Smart UV-C Technology
`
PhoneSoap uses powerful UV-C bulbs and quartz glass to sanitize 99.99% of germs with full 360-degree coverage, ensuring every surface of your items is thoroughly sanitized.

SANITIZE ANYTHING
`
PhoneSoap is perfect for sanitizing more than just your phone. From keys and earbuds to credit cards, jewelry, and even reusable face masks, this powerful UV sanitizer tackles germs on your everyday essentials with ease.

CHARGING STATION
`
PhoneSoap 3 is more than just a sanitizer—it’s a dual-port charging hub. With both USB-C and USB ports, it keeps your phone powered up while eliminating 99.99% of bacteria with UV-C light. Sanitize and charge at the same time, so your device is always clean, charged, and ready to go.
Questions?
- Tested against Salmonella, E. coli, MRSA, H1N1, Coronavirus 229E, Staphylococcus, Rhinovirus, Rotavirus.
- Sanitize Jewelry with PhoneSoap.
- How dirty is your phone.